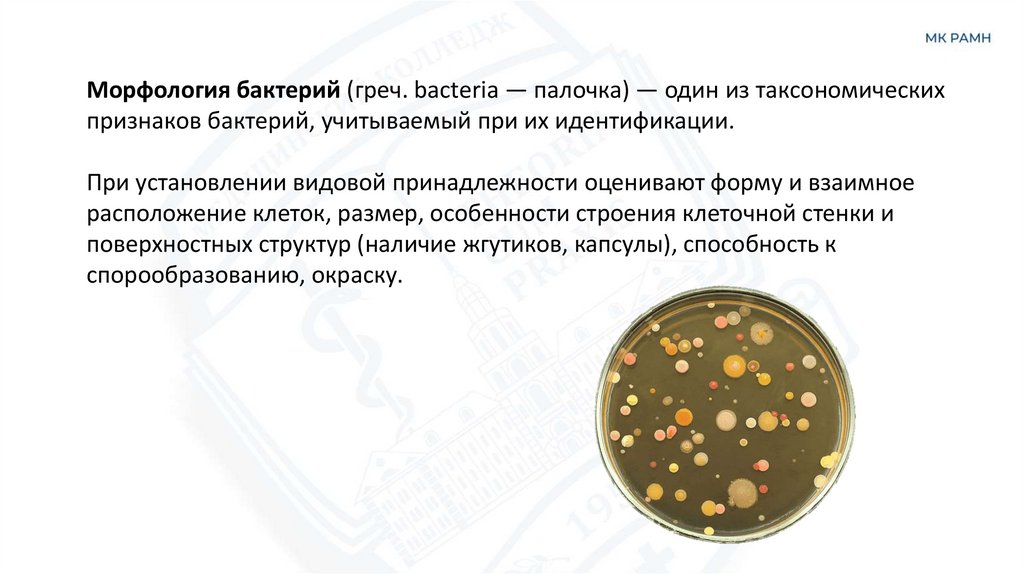

Similar presentations:
Лекция 14. Морфология бактерий
1. Лекция 14 Морфология бактерий
Преподаватель Гордеева Е.В.2.
Морфология бактерий (греч. bacteria — палочка) — один из таксономическихпризнаков бактерий, учитываемый при их идентификации.
При установлении видовой принадлежности оценивают форму и взаимное
расположение клеток, размер, особенности строения клеточной стенки и
поверхностных структур (наличие жгутиков, капсулы), способность к
спорообразованию, окраску.
3. Основные формы бактерий
1. Кокки — шаровидные бактерии (греч. coccus — зерно), диаметромпримерно 1 мкм, их взаимное расположение связано с особенностями
деления:
а) микрококки — делятся в одной
плоскости, располагаются
беспорядочно, поодиночке.
Входят в состав нормальной
микрофлоры, находятся во внешней
среде.
Заболеваний у людей не вызывают;
4. Основные формы бактерий
б) диплококки (греч. diploos — двойной) — делятся в одной плоскости,располагаются парами:
— пневмококки — ланцетовидные;
— нейссерии (гонококки и
менингококки) — бобовидные;
5. Основные формы бактерий
в) тетракокки — делятся в двух взаимноперпендикулярных плоскостях, образуя
группы по четыре особи; медицинского
значения не имеют;
г) сарцины (лат. sarcina — связка, тюк) —
делятся в трех взаимно перпендикулярных
плоскостях, и клетки после деления
остаются соединенными друг с другом,
возникают пакеты правильной кубической
формы из 8, 16 и большего количества
кокков. Часто обнаруживаются в воздухе;
непатогенны.
6.
Основные формы бактерийд) стрептококки (греч. streptos —
цепочка) — овальные, делятся в одной
плоскости, но при этом не отделяются
друг от друга и образуют цепочки.
Среди стрептококков много патогенных
микроорганизмов: возбудители
ангины, скарлатины, гнойных
воспалительных процессов, кариеса;
7.
Основные формы бактерийе) стафилококки (греч. staphylos — гроздь
винограда) — имеют форму идеального
шара, делятся беспорядочно в различных
плоскостях, образуя скопления,
напоминающие грозди винограда.
Вызывают многочисленные заболевания,
прежде всего, гнойно-воспалительные.
8.
Основные формы бактерий2. Палочки. Различаются по следующим признакам:
а) размеру:
— коккобактерии (бордетеллы, гемофилы, риккетсии);
— мелкие и средние (энтеробактерии);
— длинные палочки (бациллы);
Возбудитель коклюша
Bordetella pertussis
Возбудитель сальмонеллеза
Salmonella bongori
Сенная палочка
Bacillus Subtilis
9.
Основные формы бактерийб) форме клеток и их концов:
имеют строго цилиндрическую или овоидную форму, концы палочек могут
быть ровными, закругленными, заостренными, обрубленными;
Кишечная палочка
Fusobacterium Nucleatum
10.
Основные формы бактерийв) взаимному расположению:
– энтеробактерии — прямые,
располагаются беспорядочно;
– коринебактерии (греч. coryne —
булава) — располагаются попарно, в
виде римской цифры V или в виде
растопыренных пальцев;
Corynebacterium diphtheriae дифтерийная палочка
11.
Основные формы бактерий– клостридии (лат. clostridium — веретено)
— располагаются беспорядочно, имеют
веретенообразную форму благодаря
терминально расположенной споре;
– бациллы (имеют эндоспоры) —
располагаются цепочками.
Сlostridium tetani – возбудитель столбняка
12.
Основные формы бактерийг) способности к спорообразованию:
– бактерии — не образуют спор;
– бациллы — спорообразующие аэробы, диаметр эндоспоры обычно не
превышает ширины клетки;
– клостридии — спорообразующие анаэробы, диаметр споры больше
поперечника вегетативной клетки, в связи с этим клетка напоминает
веретено или теннисную ракетку.
13.
Основные формы бактерий3. Извитые бактерии:
– вибрионы — короткие клетки,
образуют один изгиб,
изогнутость их тел не
превышает одной четверти
оборота спирали, т. е. выглядят
наподобие изогнутых палочек
или скобочек;
Холерный вибрион
Vibrio cholerae
14.
Основные формы бактерий3. Извитые бактерии:
– спирохеты (трепонемы,
лептоспиры, боррелии) — тонкие и
длинные, имеют различное число
завитков, специфический для
различных представителей характер
движения и особенности строения;
Возбудитель сифилиса
15.
Основные формы бактерий3. Извитые бактерии:
– кампилобактерии и спириллы — длинные извитые клетки, образуют 2–3
изгиба из одного или нескольких оборотов;
Возбудитель кампилобактериоза
Campylobacter ssp.
Возбудитель Содоку – болезни «укуса крыс»
Spirillum minus
16.
Основные формы бактерий4. Ветвящиеся бактерии:
– актиномицеты (греч. actis —
луч, mykes — гриб) — ветвящиеся
клетки.
Некоторые патогенны для
человека, вступают в симбиоз с
растениями, являются
продуцентами антибиотиков.
17.
18.
19. Особенности строения микоплазм
• У них отсутствует ригиднаяклеточная стенка.
• Имеют трехслойную
липопротеиновую
цитоплазматическую
мембрану, содержащую
холестерин.
• Внутри микоплазмы содержат
ДНК, рибосомы, РНК.
20. Особенности строения микоплазм
• Мелкие, неподвижныеграмотрицательные бактерии
• Полиморфные
• Могут проходить сквозь
бактериальные фильтры
• Инфицируют дыхательные пути и
мочеполовую системы

biology
biology








